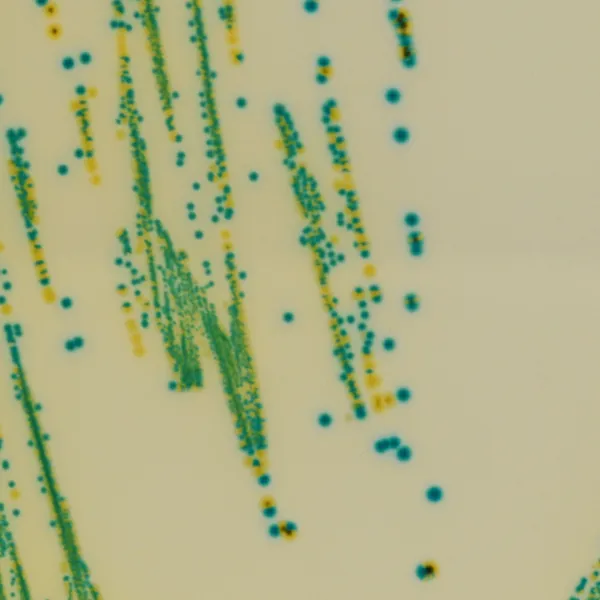
CHROMagar™ Cronobacter
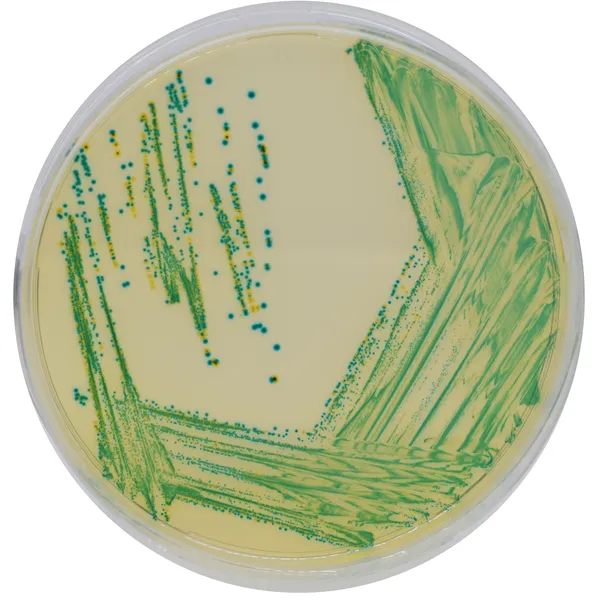
CHROMagar™ Cronobacter

Hình thái khuẩn lạc

Cronobacter spp.
màu xanh lá cây đến xanh dương

Các vi khuẩn Gram (-) khác
không màu, xanh lá trong, đen, vàng
Hiệu năng
Hiệu năng
«Cronobacter là một vi sinh vật telluric phổ biến được tìm thấy trong nước, đất, thực vật, bụi và nhiều sinh vật khác. Cronobacter đã được phân lập từ nhiều loại thực phẩm có nguồn gốc thực vật hoặc động vật, cả dạng khô, hun khói, đông lạnh, lên men, sống và chín.»
Trích từ ANSES, Tháng 4 năm 2017
CHROMagar™ Cronobacter là môi trường Chromogen để phân lập Cronobacter (CCI), được sản xuất theo tiêu chuẩn ISO 22964.
1. Tiêu chuẩn ISO 22964: CHROMagar™ Cronobacter là môi trường chromogen để phát hiện Cronobacter spp. trong thực phẩm, thức ăn chăn nuôi và mẫu môi trường theo tiêu chuẩn ISO 22964.
2. Khuẩn lạc màu xanh lá cây đậm đến xanh dương: Cronobacter spp. sẽ phát triển thành các khuẩn lạc màu xanh lá cây đến xanh dương trong khi hầu hết vi khuẩn khác sẽ bị ức chế hoặc phát triển thành các khuẩn lạc không màu, sau khi ủ ở 41.5 °C trong 24 giờ.
Thành phần

Xem thêm